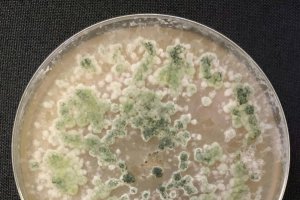
Trichorderma se reconoce muy fácilmente en la placa Petri porque es muy particular, de color muy verde y con una gran plasticidad morfológica. / L

Noticias del 9 de diciembre de 2022


Así luce el Belén hecho por vecinas de la capital de la Alpujarra
La Voz
Ubicado en la Iglesia de la Encarnación, está abierto al público desde este jueves

Así luce el Belén de la capital de la Alpujarra
La Voz
Está ubicado en la Iglesia de la Encarnación y lo han hecho las vecinas del pueblo

Detienen a dos cazadores por disparar cerca de una zona de viviendas
La Voz
Los agentes localizan en el vehículo distintas artes y armas, entre ellas dos rifles

La lluvia en Almería: caen más de 60 litros en Bayárcal
Mª Ángeles Arellano
Otros municipios como Félix pasan de los 40 litros por metro cuadrado

Más de 1 millón de euros para dotar a Roquetas de una gran zona verde
La Voz
Con esta inversión de Diputación se remodelará la Avenida de Cerrillos y su entorno

El Centro Comercial Torrecárdenas cuenta ya con un punto violeta
La Voz
El servicio está disponible en el Punto de Información

El Ayuntamiento de Berja ejecuta un nuevo tramo de la vía saludable de San Roque
La Voz
Hay en marcha una fase que actúa en la carretera de Turón eliminando la peligrosidad

El colectivo de inmigrantes de las Escuelas de Adultos de Adra reciben formación
Rosa Macer
Sobre concienciación vial y consecuencias del abuso del consumo de bebidas alcohólicas
Hongo ‘prodigio’ para salvar los bananos mexicanos y otros cultivos comerciales
Agricultura 2000
El género de hongo Trichoderma, presente en todo el mundo, ha demostrado ser muy beneficioso

“Me siento orgullosa y agradecida de formar parte de la sanidad”
Mª Ángeles Arellano
El agradecimiento a Torrecárdenas de una sanitaria tras la muerte de su padre

Un calendario ilustrado de Almería para perderse por sus lugares más bellos
La Voz
Realizado por Sara Moncada, lleva dibujos y datos de hermosas ubicaciones de la provincia

El segundo premio de la Lotería cae en un pueblo de Almería
M. R. Cárdenas
El premio son 60.000 euros al número

EN DIRECTO: Al-Nassr-UD Almería
Carlos Miralles
(1-1): El Bilal Touré marca de cabeza a centro de Portillo. Empata Talisca

Una forma de conocer Mojácar como nunca antes lo habías hecho
Guillermo Mirón
Una nueva ruta compuesta por cinco indalos especiales muestra los rincones del pueblo

Nuevas confirmaciones para el Solazo Fest: así está el cartel
La Voz
El festival se celebrará los días 28, 29 y 30 de abril

Guti: “No quiero volver a un equipo con la Liga empezada”
Carlos Miralles
Importante reflexión del que fuera técnico del Almería

Intoxicado un hombre en el incendio de su vivienda en Olula del Río
La Voz
Los servicios sanitarios evacuaron al afectado al Hospital de la Inmaculada


Entramos en la casa del Almería
Carlos Miralles
El Vittori Palace, un complejo de cinco estrellas para el equipo
Más leídas